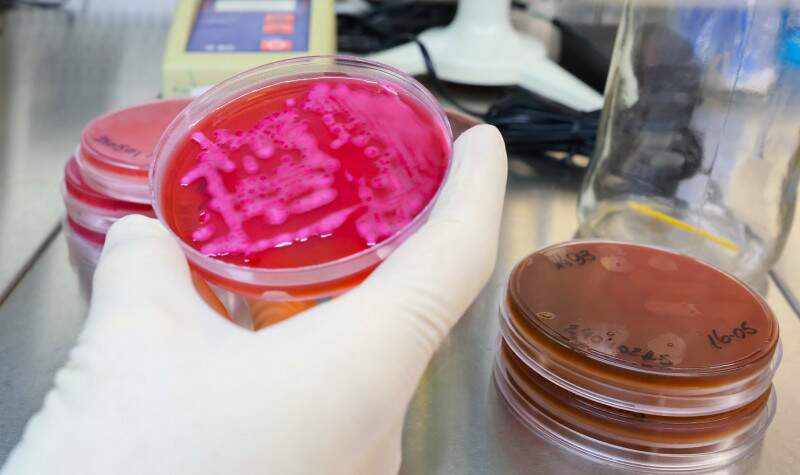

Sexta-feira, 26 de Junho de 2026
Sexta-feira, 26 de Junho de 2026
Por Redação Rádio Pampa | 24 de maio de 2024
O Laboratório Central do Estado do Rio Grande do Sul (Lacen/RS) está analisando mais de 800 amostras de casos suspeitos de leptospirose.
O serviço acompanha o crescimento no número de ocorrências devido ao grande período de enchentes que assolam o Estado e o aumento da exposição à doença pela população. O laboratório dispõe de dois diagnósticos: o de biologia molecular (RT-PCR) e o diagnóstico sorológico. Ambas testagens são feitas de forma gratuita.
Segundo dados atualizados na quinta-feira (23), já são 1.072 notificações e 54 casos confirmados de leptospirose no Rio Grande do Sul. Até aquele momento, o Estado havia contabilizado quatro casos de mortes e outros quatro óbitos em investigação.
“A realização dos exames está disponível para todos os casos considerados suspeitos e que tiveram exposição à enchente, e de forma gratuita”, ressalta a chefe do Lacen/RS, Loeci Natalina Timm. A instituição está operando de forma integral e recebe amostras das 7h às 19h.
O método RT-PCR detecta a bactéria presente no organismo do paciente e é recomendado para amostras coletadas nos primeiros sete dias de sintomas.
Já o diagnóstico sorológico detecta o anticorpo produzido pelo organismo do paciente em resposta à infecção causada pela bactéria Leptospira. A reação sorológica é a opção de escolha para análise das amostras de pacientes que apresentam sintomas há sete dias ou mais.
Leptospirose
A leptospirose é uma doença infecciosa febril aguda e transmitida a partir da exposição direta ou indireta à urina de animais (principalmente ratos) infectados. O contágio pode ocorrer a partir da pele com lesões ou mesmo em pele íntegra, se imersa por longos períodos em água contaminada, além de por meio de mucosas.
O período para o surgimento dos sintomas pode variar de um a 30 dias. Os principais sintomas são: febre, dor de cabeça, fraqueza, dores no corpo (em especial, na panturrilha) e calafrios.
Ao apresentar os sintomas, a recomendação é procurar um serviço de saúde e relatar a exposição de risco. O uso do antibiótico, conforme orientação médica, está indicado em qualquer período da doença, mas sua eficácia costuma ser maior na primeira semana do início dos sintomas. Não é necessário aguardar o diagnóstico laboratorial para o início do tratamento.
Voltar Todas de Rio Grande do Sul